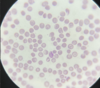
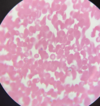

Quién descubrió la malaria?
Carlos Luis Alfonso Laverán (1880 - nobel: 1907)
Cuál es el agente etiológico de la malaria?
Plasmodium sp
Cuáles son las especies de Plasmodium que infectan al hombre?
- P. falciparum
- P. vivax
- P. ovale
- P. malariae
De qué dependen la gravedad y cuadro clínico de la malaria?
- Especie infectante
- Parasitemia
- Citocinas liberadas
De qué se alimenta el Plasmodium y que deja como residuo?
Se alimentan de globina y dejan como residuo pigmento malárico o hemozoína
En qué estadío entra el Plasmodium al eritrocito y que forma toman?
Entra como merozoito y toman una forma anillada
Después de que madura el merozoito de Plasmodium tras invadir el eritrocito, qué se forma?
Se forma un esquizonte, que se divide en merozoitos nuevamente y se repite el ciclo
Cada cuántas horas sucede la liberación de merozoitos en Plasmodium?
Vivax, ovale y falciparum: cada 48h
Malariae: cada 72h
Qué pasa con algunos de los merozoitos de Plasmodium liberados por el esquizonte?
Se diferencian a gametocitos para poder infectar al mosquito
Cómo se transmite el Plasmodium?
- Vector
- Congénita
- Transfusiones
- Transplantes
- Jeringas
Cuáles son los síntomas de Malaria?
- Dolor de cabeza
- Fiebre
- Fatiga
- Dolor muscular
- Escalofríos
- Sudoración
- Tos seca
- Inflamación de bazo
- Nausea
- Vómito
Cuánto dura el período prepatente de P. falciparum?
6-12 días
Cuánto dura el período prelatente de P. vivax y ovale?
8-12 días
Cuánto dura el período prelatente de P. malariae?
12-16 días
Cuánto dura el período de incubación de P. falciparum?
7-14 días
Cuánto dura el período de incubación de P. vivax y ovale?
8-14 días
Cuánto dura el período de incubación de P. malariae?
7-30 días
Cuál es el período de transmisibilidad de P. malariae?
Más de 3 años
Cuál es el período de transmisibilidad de P. vivax?
1-2 años
Cuál es el período de transmisibilidad de P. falciparum?
Menos de un año
Qué particularidad tiene la infección por Plasmodium vivax?
Tiene la capacidad de mantener formas durmientes como hipnozoitos en el hígado, lo que da la posibilidad de recurrencia de la enfermedad
Cuál es la complicación más grave de Plasmodium vivax?
Esplenomegalia → ruptura del bazo → hemorragia interna
Qué técnicas diagnósticas directas son usadas para diagnosticar malaria?
- Microscopía (gota gruesa y extendido)
- Naranja de acridina
- Sondas de ADN
Qué técnicas serológicas son usadas para diagnosticar malaria?
- TIF
- ELISA